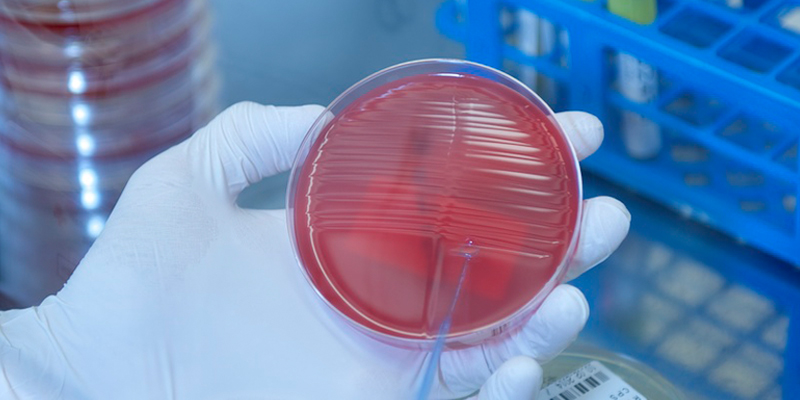

Zentrallaboratorien
Das Zentrallabor im Kantonsspital Baselland ist eine zentrale Einrichtung für die medizinische Diagnostik. Es unterstützt die Kliniken und Fachabteilungen des Spitals durch präzise Laboranalysen. Mit modernster Technologie und hoch qualifizierten Fachkräften gewährleistet das Zentrallabor eine schnelle und zuverlässige Analytik, die entscheidend für die optimale Patientenversorgung ist.
Fachbereiche
Kompetenzen
Das Zentrallabor hat ein Qualitätsmanagementsystem, das von allen Mitarbeitenden unterstützt wird. Unsere Qualitätspolitik bildet die Grundlage unseres Managementsystems. Sie ist auf die Zufriedenheit der Patientinnen und Patienten, der zuweisenden Ärztinnen und Ärzte, der medizinischen Einrichtungen und anderer Partnerunternehmen ausgerichtet.
Unsere Qualitätsziele sind:
- Optimieren der Prozesse und der Kompetenzen des Personals durch Verbesserung der Techniken und ständige Weiterbildung
- Die Zufriedenheit der Patientinnen und Patienten und unserer Partner durch qualitativ hochwertige und leistungsfähige Dienstleistungen zu erreichen
- Effiziente Labordiagnostik durch zuverlässige Analyseergebnisse und rechtzeitige Leistungserbringung
- Erfüllung aller gesetzlichen Anforderungen und Einhaltung der Norm ISO 15189 zur Anerkennung der Qualität unserer Arbeit und unserer Kompetenzen
- Förderung von Innovation im Zentrallabor und Wettbewerbsfähigkeit als Institution
- Mit hoch qualifizierten Partnerlaboren zusammenzuarbeiten
Im Rahmen unserer Nachwuchsförderung bieten wir Ausbildungsplätze für Biomedizinische Analytikerinnen und Analytiker HF (BMA) an. Mit dieser Ausbildung erlangen Sie fundiertes Fachwissen und praktische Anwendung in den Bereichen Laboranalytik und Diagnostik im medizinischen Labor. Diese beinhalten die Untersuchung von Blutproben, Harnanalysen und mikrobiologische Untersuchungen. Sie liefern mit den Laboranalysen die Grundlage dafür, Krankheiten zu erkennen und die richtige Therapie und Überwachung unserer Patientinnen und Patienten zu ermöglichen. Dies eröffnet Ihnen eine vielseitige und verantwortungsvolle berufliche Laufbahn im Gesundheitswesen.
Die Ausbildung erfolgt in Zusammenarbeit mit dem BzG Bildungszentrum Gesundheit Basel-Stadt. Sie umfasst eine dreijährige Ausbildungszeit mit Abschluss Diplom HF (Höhere Fachschule). Während dieser Zeit sind Sie abwechselnd am BzG und in einem unserer Laborbetriebe im mehrmonatigen Praktikum. Sie profitieren von einer praxisnahen Ausbildung durch unsere Berufsexpertinnen und -experten am Praktikumsort sowie von den Lehrpersonen an der Schule. Dadurch werden Sie optimal auf Ihre Rolle als BMA HF vorbereitet.
Die Ausbildung beinhaltet den Umgang mit modernen Geräten und Technologien und Sie lernen, wie wichtig Qualität und Präzision in der Laborarbeit ist. Sie arbeiten eng mit Ärztinnen und Ärzten, Pflegefachpersonen und anderen Fachleuten zusammen. Kommunikation und Teamarbeit sind daher wichtige Kompetenzen.
Unsere Laboratorien umfassen folgende Fachbereiche: Hämatologie, Immunologie, Mikrobiologie und Klinische Chemie. Wir sind bestrebt, unseren Auszubildenden ein möglichst breites Spektrum in der Laboranalytik zu bieten.
Haben Sie Fragen zur Ausbildung? Unsere Berufsbildungsverantwortliche gibt Ihnen gerne Auskunft:
Aline Stalder
Berufsbildungsverantwortliche Zentrallaboratorien
+41 61 400 25 57
E-Mail schreiben
Mit regelmässigen internen und externen Weiterbildungsveranstaltungen für alle Mitarbeitende der Zentrallaboratorien entwickeln wir unsere Fachkenntnisse kontinuierlich weiter.
Gut zu wissen
Öffnungszeiten Zentrallaboratorien
Routinebetrieb Montag-Freitag 08.00-17.00 Uhr
Notfallbetrieb 24/7
Öffnungszeiten Mikrobiologie
Routinebetrieb Montag-Freitag 08.00-17.00 Uhr
sowie Samstag, Sonntag und Feiertage 08.00-12.00 Uhr
Probenannahme 24/7
Kontakt Liestal (24/7)
+41 61 400 25 55
E-Mail schreiben
Kontakt Bruderholz (24/7)
+41 61 400 32 10
E-Mail schreiben
Kontakt für administrative Fragen
Haben Sie Fragen, Rückmeldungen oder wünschen Sie weitere Informationen? Zögern Sie nicht, uns zu kontaktieren. Wir freuen uns auf Ihre Anfrage.
Auftragsformular Externe: Liestal
Auftragsformular Externe: Bruderholz
Einsenden von Stuhl für Calprotectin
Einsenden von Stuhl für Multiplex PCR
Einsenden von Stuhl für Okkultes Blut
Information für Patientinnen und Patienten
- Bitte beachten Sie, dass die Beurteilung ihres Befundes von Ihrer Ärztin/Ihrem Arzt vorgenommen werden soll.
Die Labormedizin untersteht der Meldepflicht des BAG.